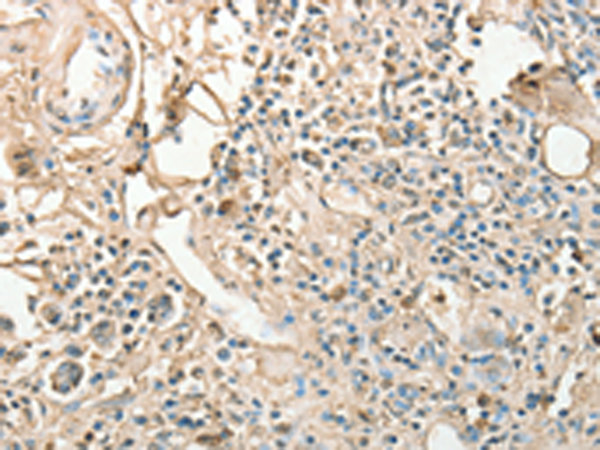
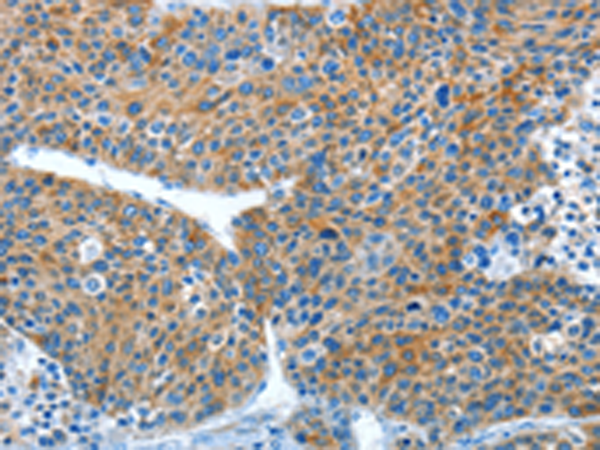

-
分类: 科研抗体货号: P07794别名: GA; AGU; ASRG应用: WB,IHC反应种属: Human, Mouse, Rat
-
分类: 科研抗体货号: P07795别名: CCP2应用: WB,IHC反应种属: Human
-
分类: 科研抗体货号: P07793别名: AFAP; AFAP110; AFAP-110应用: WB,IHC反应种属: Human, Mouse, Rat
-
分类: 科研抗体货号: P07813别名: ALDH4; ALDH7应用: WB,IHC反应种属: Human, Mouse, Rat
-
分类: 科研抗体货号: P07824别名: PI; A1A; AAT; PI1; A1AT; PRO2275; alpha1AT应用: IHC反应种属: Human
-
分类: 科研抗体货号: P07812别名: ALDH3; ALDHIII应用: WB,IHC反应种属: Human, Mouse, Rat
-
分类: 科研抗体货号: P07822别名: ORM; AGP1; AGP-A应用: WB,IHC反应种属: Human
-
分类: 科研抗体货号: P07811别名: FDH; FTHFD; 10-fTHF; 10-FTHFDH应用: WB反应种属: Human, Mouse, Rat
-
分类: 科研抗体货号: P07819别名: CDGIi; NET38; hALPG2应用: IHC反应种属: Human, Mouse
-
分类: 科研抗体货号: P07808别名: ALAS; MIG4; ALAS3; ALASH应用: IHC反应种属: Human, Mouse, Rat

鄂公网安备42018502007531号
鄂公网安备42018502007531号

